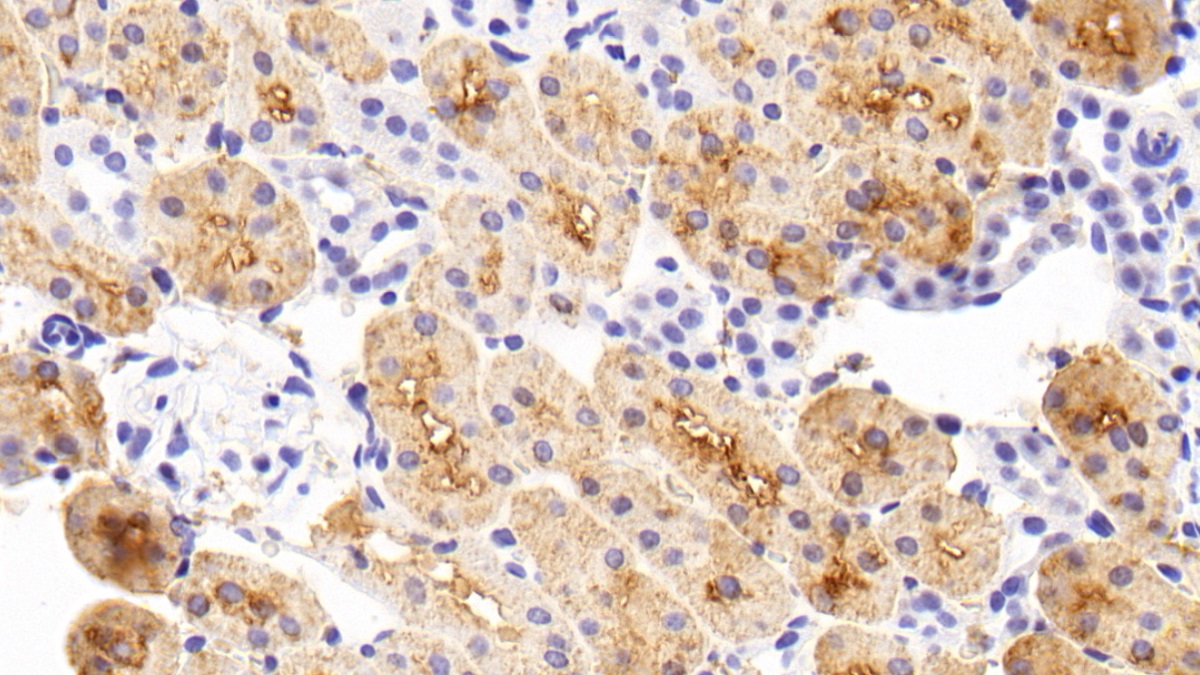

Monoclonal Antibody to Cyclophilin A (CYPA)
PPIA; CyP-A; CYPH; Peptidylprolyl Isomerase A; Peptidyl-Prolyl Isomerase A; Peptidyl-prolyl cis-trans isomerase A; Cyclosporin A-binding protein
- Product No.MAA979Ra27
- Organism SpeciesRattus norvegicus (Rat) Same name, Different species.
- SourceMonoclonal antibody preparation
- HostMouse
- Potency (Clone Number)C14
- Ig Isotype IgG1 Kappa
- PurificationProtein A + Protein G affinity chromatography
- LabelNone
- Immunogen RPA979Ra01-Recombinant Cyclophilin A (CYPA)
- Buffer Formulation0.01M PBS, pH7.4, containing 0.05% Proclin-300, 50% glycerol.
- TraitsLiquid
- Concentration1mg/ml
- Organism Species MoreHomo sapiens (Human)
- ApplicationsWB; IHC
If the antibody is used in flow cytometry, please check FCM antibodies. - DownloadInstruction Manual
- UOM 20µl100µl 200µl 1ml 10ml
- FOB
US$ 112
US$ 260
US$ 372
US$ 930
US$ 3720
For more details, please contact local distributors!
SPECIFITY
The antibody is a mouse monoclonal antibody raised against CYPA. It has been selected for its ability to recognize CYPA in immunohistochemical staining and western blotting.
USAGE
Western blotting: 0.5-2µg/mL;
Immunohistochemistry: 5-20µg/mL;
Immunocytochemistry: 5-20µg/mL;
Optimal working dilutions must be determined by end user.
STORAGE
Store at 4°C for frequent use. Stored at -20°C in a manual defrost freezer for two year without detectable loss of activity. Avoid repeated freeze-thaw cycles.
STABILITY
The thermal stability is described by the loss rate. The loss rate was determined by accelerated thermal degradation test, that is, incubate the protein at 37°C for 48h, and no obvious degradation and precipitation were observed. The loss rate is less than 5% within the expiration date under appropriate storage condition.
GIVEAWAYS
INCREMENT SERVICES
-
 Antibody Labeling Customized Service
Antibody Labeling Customized Service
-
 Protein A/G Purification Column
Protein A/G Purification Column
-
 Staining Solution for Cells and Tissue
Staining Solution for Cells and Tissue
-
 Positive Control for Antibody
Positive Control for Antibody
-
 Tissue/Sections Customized Service
Tissue/Sections Customized Service
-
 Phosphorylated Antibody Customized Service
Phosphorylated Antibody Customized Service
-
 Western Blot (WB) Experiment Service
Western Blot (WB) Experiment Service
-
 Immunohistochemistry (IHC) Experiment Service
Immunohistochemistry (IHC) Experiment Service
-
 Immunocytochemistry (ICC) Experiment Service
Immunocytochemistry (ICC) Experiment Service
-
 Flow Cytometry (FCM) Experiment Service
Flow Cytometry (FCM) Experiment Service
-
 Immunoprecipitation (IP) Experiment Service
Immunoprecipitation (IP) Experiment Service
-
 Immunofluorescence (IF) Experiment Service
Immunofluorescence (IF) Experiment Service
-
 Buffer
Buffer
-
 DAB Chromogen Kit
DAB Chromogen Kit
-
 SABC Kit
SABC Kit
-
 Long-arm Biotin Labeling Kit
Long-arm Biotin Labeling Kit
-
 Real Time PCR Experimental Service
Real Time PCR Experimental Service
| Magazine | Citations |
| Atherosclerosis | EMMPRIN and its ligand cyclophilin A regulate MT1-MMP, MMP-9 and M-CSF during foam cell formation PubMed: 19758589 |
| Biomarkers | Cyclophilin-A: a novel biomarker for untreated male essential hypertension Pubmed: 24164594 |
| Cardiovascular Diabetology | Plasma level of cyclophilin A is increased in patients with type 2 diabetes mellitus and suggests presence of vascular disease Pubmed:24502618 |
| International Journal of Biological Sciences | Decrease in Plasma Cyclophilin A Concentration at 1 Month after Myocardial Infarction Predicts Better Left Ventricular Performance and Synchronicity at 6 Months: A Pilot Study in Patients with ST Elevation Myocardial Infarction Pubmed:25552928 |
| Medicine | Cyclophilin A in Ruptured Intracranial Aneurysm PubMed: 26426668 |
| Mol Cell Biochem | PPIA rs6850: A> G single-nucleotide polymorphism is associated with raised plasma cyclophilin A levels in patients with coronary artery disease PubMed: 26702934 |
| Medicine (Baltimore) | Urinary Cyclophilin A as a New Marker for Diabetic Nephropathy: A Cross-Sectional Analysis of Diabetes Mellitus PubMed: 26496315 |
| International Journal of Cardiology | Cyclophilin A modulates bone marrow-derived CD117(+) cells and enhances ischemia-induced angiogenesisvia the SDF-1/CXCR4 axis. Pubmed:27057951 |
| Clinica Chimica Acta | Novel findings of secreted cyclophilin A in diabetic nephropathy and its association with renal protection of dipeptidyl peptidase 4 inhibitor pubmed:27823952 |
| Cardiovascular Diabetology | Cyclophilin A enhances macrophage differentiation and lipid uptake in high glucose conditions: a cellular mechanism for accelerated macro vascular disease in diabetes mellitus. pubmed:27809851 |
| Clinical Science | Metformin attenuates effects of cyclophilin A on macrophages, reduces lipid uptake and secretion of cytokines by repressing decreased AMPK activity Pubmed:29382697 |
| Journal of Molecular Histology | Cyclophilin a increases CD68 cell infiltration in rat experimental periodontitis Pubmed:29318411 |
| Free Radical Research | Cyclophilin A and CD147 associate with progression of diabetic nephropathy Pubmed: 30572748 |
| The Kaohsiung Journal of Medical Sciences | Association of cyclophilin A level and pulse pressure in predicting recurrence of cerebral infarction Pubmed: 31670477 |
| Cells. | Cyclophilin A/EMMPRIN Axis Is Involved in Pro-Fibrotic Processes Associated with Thoracic Aortic Aneurysm of Marfan Syndrome Patients Pubmed: 31936351 |
| JAMA Neurology | APPENDIX A: Relationship between cyclophilin A levels and matrix metalloproteinase-9 activity in cerebrospinal fluid of cognitively normal apolipoprotein E4 carriers … Pubmed: 24030206 |
| Menoufia Medical Journal | Urinary podocalyxin and cyclophilin A: markers for early detection of type 2 diabetic nephropathy |
| Toxins | Evaluation of the Therapeutic Effects of Protocatechuic Aldehyde in Diabetic Nephropathy 34437430 |
| Cell Death & Disease | Proteomic analysis reveals USP7 as a novel regulator of palmitic acid-induced hepatocellular carcinoma cell death Pubmed:35732625 |